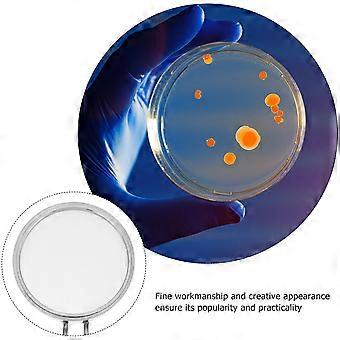

Peneira de teste de filtro de célula de aço inoxidável 200 Mesh Cell com alça
Envio GRATUITO

Peneira de teste de filtro de célula de aço inoxidável 200 Mesh Cell com alça
- Marca: Unbranded
Peneira de teste de filtro de célula de aço inoxidável 200 Mesh Cell com alça
- Marca: Unbranded
Economize 28,00 € (70%)
PVP
Economize 28,00 € (70%)
PVP
Aceitamos as seguintes formas de pagamento
Descrição
Peneira de teste de filtro de célula de aço inoxidável 200 Mesh Cell com alça
- Marca: Unbranded
- Categoria: Peneiras de Farinha
-
Cor: Prata
-
Tamanho: 15X5,7 centímetros
- Identificação da Fruugo: 261444404-572270273
- EAN: 4381071448219
Informações de segurança do produto
Consulte as informações de segurança do produto específicas para este produto descritas abaixo
As informações a seguir são fornecidas pelo revendedor independente que vende este produto.
Etiquetas de segurança do produto

Entrega e Devoluções
Enviado dentro de 2 dias
-
STANDARD: GRÁTIS - Entrega entre quinta 18 dezembro 2025–quinta 25 dezembro 2025 - GRÁTIS
Enviamos a partir de China.
Fazemos o nosso melhor para garantir que os produtos que encomendar lhe serão entregues na totalidade e conforme as suas especificações. No entanto, se receber uma encomenda incompleta ou itens diferentes dos que encomendou, ou existir qualquer outra razão pela qual não estiver satisfeito com a sua encomenda, poderá devolver a encomenda ou quaisquer produtos incluídos na mesma, e receber um reembolso total dos itens. Ver a política de devoluções na íntegra
Detalhes de conformidade do produto
Consulte as informações de conformidade específicas para este produto descritas abaixo.
As informações a seguir são fornecidas pelo revendedor independente que vende este produto.
Fabricante:
As informações seguintes apresentam os dados de contacto do fabricante do produto em causa vendido na Fruugo.
- Shenzhen Daguangyutong Trading Co., Ltd.
- Shenzhen Daguangyutong Trading Co., Ltd.
- Room 619, Floor 6, Building D, Bailian Qimengcheng, No. 11 Shuitian 1st Road, Longgang Street, Longgang District, Shenzhen
- Shenzhen
- CN
- 518000
- DYGTliuc@hotmail.com
- 18128580114
Pessoa responsável na UE:
As informações seguintes apresentam os dados de contacto da pessoa responsável na UE. A pessoa responsável é o operador económico designado, sedeado na UE, incumbido das obrigações de conformidade relativas ao produto em causa vendido na União Europeia.
- MARWAY Consulting UG (haftungsbeschrankt)
- MARWAY Consulting UG (haftungsbeschrankt)
- Am Maibusch 108 -110,45883, Gelsenkirchen, Germany
- Gelsenkirchen
- DE
- 45833
- MARWAY.UG@outlook.com
- 4917645084650